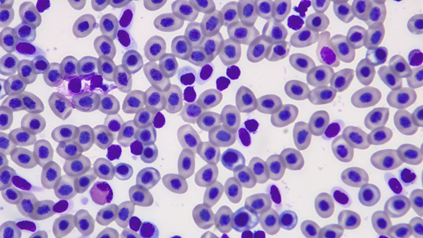

Россия
Россия
Россия
Россия
Условия выращивания осетровых рыб оказывают влияние на их рост и физиологическое состояние, морфологические признаки. Изучение изменений физиологических процессов при воздействии комплекса факторов в условиях садков и систем замкнутого водоснабжения позволит проводить своевременную корректировку технологии и снижать риски при выращивании товарной продукции. В ремонтно-маточных стадах рыбоводных предприятий содержатся разновозрастные особи стерляди, которые ежегодно при достижении половой зрелости входят в рыбоводный процесс в качестве производителей. Исследованы основные морфофизиологические показатели двухлеток, содержащихся в садках и в установках замкнутого водоснабжения (УЗВ). Влияние факторов среды обитания отмечено не только на ростовые показатели, но и на размеры внутренних органов рыб и их состояние. Нестабильный температурный режим в садках, зависимость от непрогнозируемых изменений гидрохимических показателей водной среды способствуют глубоким физиологическим преобразованиям адаптивного характера, что замедляет темп роста и кумуляцию резервных веществ. Очевидными были и изменения морфометрических показателей. У осетровых рыб наблюдается повышение относительной массы сердца, селезенки и гонад, снижение массы почек и печени. Отмечено влияние оптимальных температурного и гидрохимического режимов на индекс желудочно-кишечного тракта, который у рыб из УЗВ был несколько ниже, чем у особей, испытывающих воздействие природных факторов в садках. Показатели крови стерляди вне зависимости от условий содержания соответствовали физиологической норме. Создание оптимальных гидрологических и трофических условий в УЗВ способствует накоплению в тканях фосфолипидов и жирных кислот линоленового ряда, играющих важную роль в адаптации организма к негативным факторам внешней среды.
стерлядь, физиологическое состояние, условия выращивания, морфофизиологические показатели, индексы внутренних органов, кровь, липиды, жирные кислоты
Введение
Одним из наиболее распространенных объектов выращивания в товарном осетроводстве является стерлядь, обладающая высокой степенью адаптивности к внешним условиям, более раним, в отличие от других видов осетровых, созреванием, небольшим интервалом между нерестами, высоким темпом роста, ценными потребительскими свойствами. Выращивание данного вида осетровых рыб проводят как в условиях садковых хозяйств, так и в установках замкнутого водоснабжения (УЗВ), а также в прудах и небольших водоемах. Условия выращивания оказывают значительное влияние на рост и состояние рыб, их морфологические признаки.
В настоящее время интенсивность загрязнения промышленными и сельскохозяйственными стоками естественной среды обитания рыб постоянно возрастает [1], что ведет к регрессу сложившихся биоценозов и, зачастую, к необратимым изменениям физиологического состояния особей. Постоянное присутствие загрязнителей в водной среде препятствует нормальному росту и развитию организма рыб, способствует возникновению аномалий и нарушению обменных процессов. Подобное влияние на организм рыб оказывают и факторы стресса, которые являются неотъемлемой частью рыбоводного процесса [2]. Таким образом, в товарном осетроводстве в условиях садковых предприятий на состояние выращиваемых объектов негативное воздействие оказывает комплекс факторов антропогенной природы, которые способствуют нарушению гомеостаза внутренней среды организма рыб, проявляющемуся
в изменении морфофизиологических показателей и снижении их продуктивных качеств.
Высокая способность стерляди адаптироваться к изменяющимся факторам внешней среды позволяет компенсировать степень воздействия и предотвратить критические изменения физиологического состояния. Адаптационный потенциал организма зависит от особенности метаболизма в тот или иной период жизненного цикла [2]. Этот факт свидетельствует о регулярной трансформации обменных процессов в организме рыб не только в течение жизни, но и в результате постоянного воздействия внешних факторов. В раннем периоде постэмбриогенеза обмен веществ в организме направлен на накопление и использование пищевых нутриентов на рост и развитие, в период созревания энергетический потенциал направлен на формирование гонад [3, 4]. Изучение изменений физиологических процессов при воздействии комплекса факторов в условиях садковых комплексов и систем замкнутого водоснабжения позволит проводить своевременную корректировку технологии выращивания и снижать риски при получении товарной продукции.
Целью исследований является изучение морфофизиологических показателей стерляди, выращиваемых в условиях садковых хозяйств и при регулируемых условиях водной среды УЗВ.
Материал и методы исследований
Основой представленных материалов являются обобщенные многолетние данные, собранные на садковых хозяйствах Нижней Волги и в УЗВ (уникальной научной установке (УНУ) НТИ РФ Рег. № 3662433) «Научно-исследовательский комплекс передовых технологий аквакультуры и гидроэкологии» факультета биотехнологий и рыбного хозяйства Московского государственного университета технологий и управления имени К. Г. Разумовского (ПКУ).
Объектом исследования являлись двухлетки стерляди, содержащиеся в садках и в условиях УЗВ, средней массой 318,1 ± 15 и 335,5 ± 25 г соответственно. Для исследований отбиралось по 20 особей без видимых повреждений.
Оценку физиологического состояния стерляди проводили по основным гематологическим и физиолого-биохимическим показателям. Отбор крови у рыб осуществляли из хвостовой артерии прижизненным способом. Содержание гемоглобина в крови измеряли фотометрическим методом. Среднюю концентрацию гемоглобина в эритроците рассчитывали по И. И. Гительзону и И. А. Терскову [5], подсчет эритроцитов – в камере Горяева, скорость оседания эритроцитов – в аппарате Панченкова. Определение клеток осуществляли по классификации Н. Т. Ивановой [6]. Общий сывороточный белок определяли рефрактометрически.
Химический состав тканей рыб анализировали стандартными методами [7]. Для извлечения общих липидов применяли модифицированный метод, основанный на технике Блайя и Дайера. Липиды далее разделяли на классы с использованием тонкослойной хроматографии, а их разгонку осуществляли в системе растворителей [8]. Фосфолипиды разделяли на колонках с модифицированными целлюлозами. Концентрацию холестерина определяли методом Либермана – Бурхарда, а эфиры стеринов – по реакции с хромотроповой кислотой, следуя методике, указанной в работе Н. А. Абросимовой и соавторов [9].
Результаты исследований
В ремонтно-маточных стадах рыбоводных предприятий содержатся разновозрастные особи стерляди, которые ежегодно при достижении половой зрелости входят в рыбоводный процесс в качестве производителей. В связи с этим нами исследованы основные морфофизиологические показатели двухлеток, содержащихся в садках и в УЗВ. Содержание рыб в садках происходит при естественном температурном режиме, в условиях, способствующих реализации природного потенциала роста и развития. В УЗВ в условиях оптимального термического режима и сбалансированного кормления интенсивность обменных процессов повышается, что способствует увеличению интенсивности роста рыб [10], сокращению межнерестового интервала [11]. Влияние факторов среды обитания отмечено не только на ростовые показатели, но и на размеры внутренних органов рыб и их состояние.
Исследованные двухлетки стерляди, содержащиеся в условиях садковых хозяйств, по степени накопления питательных веществ были менее упитанными. Коэффициент упитанности этих рыб был в среднем на 14 % ниже, чем у особей, выращенных и содержащихся в условиях УЗВ. Нестабильный температурный режим в садках, зависимость от непрогнозируемых изменений гидрохимических показателей водной среды способствуют глубоким физиологическим преобразованиям адаптивного характера, что замедляет темп роста и кумуляцию резервных веществ.
Очевидными были и изменения морфометрических показателей. Индекс печени рыб, выращенных при нерегулируемом гидрологическом режиме, был ниже на 12 % и соответствовал в среднем 2,23 ± 0,41 %. При замкнутом цикле водообеспечения в условиях с регулируемыми основными показателями качества водной среды гепатосоматический индекс в среднем составлял 2,87 ± 0,15 %. Противоположная закономерность выявлена при изучении кардиосоматических индексов. Наибольший индекс сердца отмечен у рыб в садковых хозяйствах. Его величина была выше на 20 %, чем у рыб из установки с замкнутым циклом водообеспечения. Полученные результаты согласуются с ранее опубликованными сведениями Т. В. Бехтеревой [12], Д. Ф. Нгуен [13], которые утверждают, что стрессовые факторы оказывают влияние на морфометрические показатели, проявляющееся в повышении относительной массы сердца, селезенки и гонад, снижении массы почек и печени. Морфофизиологические показатели стерляди, содержащейся в УЗВ и садках, представлены на рис. 1.

Рис. 1. Морфофизиологические показатели стерляди, содержащейся в УЗВ и садках
Fig. 1. Morpho-physiological parameters of sterlet kept in CWSI and cages
Отмечено влияние оптимальных температурного и трофического режимов на индекс желудочно-кишечного тракта. У рыб из УЗВ индекс ЖКТ был несколько ниже, чем у особей, испытывающих воздействие негативных факторов в садках. Данное обстоятельство объясняется опережающим увеличением длины тела относительно роста кишечника, что обусловлено высокой эффективностью усваивания питательных веществ корма и метаболизма рыбы.
Таким образом, проведенные исследования доказывают влияние неблагоприятных факторов внешней среды в условиях садкового выращивания, главным образом температуры воды, на морфометрические показатели внутренних органов стерляди.
Воздействие на рыб внешних факторов среды приводит к изменению скорости и характера обменных процессов, переход которых за пределы адаптационной способности организма приводит к патологическим нарушениям и, как следствие, к гибели рыб [14, 15]. Неблагоприятные условия среды обитания рыб, вызывающие стресс, сопровождаются изменениями состава крови, которые наиболее точно отражают физиологическое состояние и наличие патологических изменений. Комплексное исследование гематологических показателей рыб позволяет своевременно выявить дисбаланс в организме и правильно диагностировать заболевание [16].
Показатели красной крови стерляди из садковых хозяйств находились в пределах физиологической нормы здоровых рыб. Содержание гемоглобина в крови колебалось в пределах от 77,1 ± 0,7 до 81,4 ± ± 0,5 г/л, количество эритроцитов – от 0,902 · 106 до 1,02 · 106 кл/мкл. Реакция оседания эритроцитов свидетельствовала об отсутствии воспалительных процессов в организме рыб и соответствовала нормальным значениям (2,6–3,4 мм/ч). Показатели крови стерляди из УЗВ соответствовали показателям физиологически здоровых особей [17].
Форменный состав элементов периферической крови стерляди в УЗВ и при садковом выращивании представлен на рис. 2 и в табл. 1.
а б
Рис. 2. Картина крови особей стерляди, выращиваемых в садках (а) и УЗВ (б)
Fig. 2. Blood sample of sterlet individuals cultured in cages (a) and CWSI (б)
Таблица 1
Table 1
Гематологические показатели ремонтной группы стерляди, %
Hematological parameters of the sterlet repair group, %
|
Показатель |
Группа |
|
|
УЗВ |
Садки |
|
|
Лимфоциты |
86,1 ± 1,3 |
85,65 ± 1,6 |
|
Моноциты |
3,42 ± 0,8 |
3,3 ± 0,5 |
|
Нейтрофилы |
7,8 ± 0,30 |
7,9 ± 0,66 |
|
Эозинофилы |
3,1 ± 0,55 |
3,5 ± 0,3 |
|
Тромбоциты |
1,9 ± 0,3 |
2,1 ± 0,4 |
Существенной разницы по относительному количеству элементов белой крови у стерляди при разных режимах выращивания выявлено не было. При этом количество эозинофилов у рыб в условиях садкового содержания было несколько выше, что может быть обусловлено стимуляцией иммунного ответа на неблагоприятные факторы водной среды.
Количество сывороточного белка зависело от условий содержания рыб. Наличие факторов стресса при садковом выращивании способствовало снижению этого показателя до 27,3 г/л. Существенное снижение показателя общего сывороточного белка в крови приводит к снижению жизнестойкости рыб и патологическим нарушениям физиологических процессов. Количество белка в крови рыб, содержащихся в оптимальных условиях УЗВ, колебалось в незначительных пределах и составляло в среднем от 30,1 до 35,3 г/л, что свидетельствует о нормальном состоянии здоровья выращиваемых рыб при благоприятных режимах содержания и кормления.
Биохимический состав тела стерляди из садкового хозяйства отличался большим количеством белка в сухом веществе и низким уровнем липидов. По показателям биохимического состава тела состояние рыб как в садках, так и в УЗВ оценивается удовлетворительным (рис. 3).

Рис. 3. Биохимический состав тканей ремонтной группы стерляди
Fig. 3. Biochemical composition of tissues of sterlet breeding group
Содержание фосфолипидов в общих липидах тканей стерляди, содержащейся в УЗВ и садках, составляло 41,3 и 39,8 % соответственно. На рис. 4 представлены результаты исследования состава общих липидов тела двухлеток стерляди.
В липидах тканей рыб, выращенных в УЗВ, наблюдалось повышение концентрации жирных кислот линоленового ряда на 7 %, что обусловлено условиями содержания (табл. 2).

Рис. 4. Общие липиды тканей ремонтной группы стерляди
Fig. 4. Common lipids of sterlet repair group tissues
Таблица 2
Table 2
Состав жирных кислот стерляди, выращиваемой в УЗВ и в садковых хозяйствах, %
The composition of fatty acids of sterlet grown in CWSI and in the conditions of cage farms, %
|
Условия |
Жирные кислоты |
|||||
|
Насыщенные |
Ненасыщенные |
|||||
|
Моноеновые |
Полиеновые |
Σ ω3 |
Σ ω6 |
ω3 / ω6 |
||
|
УЗВ |
34,5 ± 1,8* |
32,1 ± 1,0 |
33,4 ± 1,2 |
17,4 ± 0,3* |
16,0 ± 0,4 |
1,1 |
|
Садки |
32,4 ± 1,2* |
33,4 ± 0,8 |
34,2 ± 1,1 |
18,5 ± 0,6* |
15,7 ± 0,5 |
1,2 |
* Достоверность различий p < 0,05.
Высокая степень обеспеченности фосфолипидов полиненасыщенными жирными кислотами линоленового ряда стимулирует защитные механизмы, увеличивая устойчивость организма к различным заболеваниям и обеспечивая реализацию адаптивных процессов к стрессовым факторам [18].
Полученные гематологические и биохимические показатели соответствуют ранее опубликованным результатам исследований Г. Ф. Металлова, В. М. Распопова и др. [19], А. А. Корчунова и др. [11], А. Б. Ахмеджановой с соавторами [16] и др.
Заключение
Определена зависимость состава жирных кислот в тканях стерляди от условий выращивания. Создание оптимальных гидрологических и трофических условий в установках замкнутого водоснабжения способствует накоплению в тканях фосфолипидов и жирных кислот линоленового ряда, играющих важную роль в адаптации организма к негативным факторам внешней среды. В целом физиологическое состояние исследуемых особей стерляди, содержащихся в ремонтных стадах при различных гидрологических условиях, было удовлетворительным.
1. Аманов Ш. М., Евдокимов Е. В. Состояние осетровых рыб в Каспийском море // Universum: химия и биология. 2022. № 12-1 (102). С. 15–18.
2. Шульман Г. Е. Физиолого-биохимические особенности годовых циклов рыб. М.: Пищ. пром-сть, 1972. 367 с.
3. Шатуновский М. И. Экологические закономерности обмена веществ морских рыб. М.: Наука, 1980. 283 с.
4. Металлов Г. Ф., Пономарева Е. Н., Сорокина М. Н., Григорьев В. А., Корчунов А. А. Функциональная направленность биохимических процессов у самок гибрида стерлядь × белуга (Acipenser ruthenus Linnaeus, 1758 × Huso huso Linnaeus, 1758) в репродуктивном цикле // Докл. Акад. наук. 2018. Т. 478. № 6. С. 727–729.
5. Гительзон И. И., Терсков И. А. О способе выражения гемоглобина в эритроците // Лабораторное дело. 1956. № 6. С. 6–10.
6. Иванова Н. Т. Атлас клеток крови рыб. М.: Пищ. пром-сть, 1983. 80 с.
7. Щербина М. А. Методические указания по физиологической оценке питательной ценности кормов для рыб. М.: Изд-во ВНИИПРХ, 1983. 83 с.
8. Алексеев С. М., Тараблин М. Б., Сарычева И. К., Евстигнеева Р. П. Газохроматографический анализ метиловых эфиров жирных кислот на колонках со смешанным сорбентом // Хим.-фармацевт. журн. 1981. Т. 15. С. 118–122.
9. Абросимова Н. А., Абросимов С. С., Саенко Е. Н. Кормовое сырье и добавки для объектов аквакультуры. Ростов н/Д.: Эверест, 2005. 144 с.
10. Хрусталев Е. И., Молчанова К. А., Абдулрахман З. Х. Особенности раскрытия ростовой потенции у разных объектов аквакультуры // Водные биоресурсы, аквакультура и экология водоемов: тр. V Балт. мор. форума. Всерос. науч. конф. (Калининград, 23–24 мая 2017 г.). Калининград: Изд-во КГТУ, 2017. С. 154–158.
11. Корчунов А. А., Металлов Г. Ф., Григорьев В. А., Ковалева А. В. Динамика биохимического состава тела и половых продуктов стерляди (Acipenser ruthenus Linnaeus, 1758) естественных популяций и выращенных в установках замкнутого водоснабжения // Вестн. Астрахан. гос. техн. ун-та. Сер.: Рыбное хозяйство. 2012. № 1. С. 136–143.
12. Бехтерева Т. В. Эколого-физиологические исследования. М.: Наука, 1998. 121 с.
13. Нгуен Д. Ф., Курманбаев А. Б. Качественный состав осетра, мигрирующего в р. Волгу в 2005 г. // Тез. докл. IX Ежегод. науч. конф. студентов и аспирантов базовых кафедр Юж. науч. центра РАН (Ростов-на-Дону, 11–24 апреля 2013 г.). Ростов н/Д., 2013. С. 46.
14. Моисеенко Т. И. Изменение стратегии жизненного цикла рыб под воздействием хронического загрязнения вод // Экология. 2002. № 1. С. 50–60.
15. Файзулина Д. Р., Базелюк Н. Н., Аксенов В. П. Некоторые аспекты патологичных значений биохимических показателей крови воблы Rutilus rutilus caspicus и леща Abramis brama в современных экологических условиях Волжско-Каспийского бассейна // Тр. ВНИРО. 2016. Т. 162. С. 20–27.
16. Ахмеджанова А. Б., Пономарев С. В., Вятчин В. В., Федоровых Ю. В., Левина О. А., Дутиков Е. А. Оценка биоиндикаторов физиолого-биохимических показателей ремонтно-маточного стада осетровых рыб // Рыбное хозяйство. 2021. № 5. С. 97–100. DOI:https://doi.org/10.37663/0131-6184-2021-5-97-100.
17. Asadi F., Masoudifard M., Vajhi A., Lee K., Pourkabir M., Khazraeiniaet P. Serum biochemical parameters of Acipenser persicus // Fish Physiology and Biochemistry. 2006. V. 32. P. 43–47.
18. Фокина Н. Н., Лысенко Л. А., Руоколайнен Т. Р., Суховская И. В. Зависимость содержания липидов и ненасыщенных жирных кислот в скелетных мышцах радужной форели от условий выращивания и физиологического состояния рыб // Прикладная биохимия и микробиология. 2020. Т. 56. № 3. С. 305–312.
19. Металлов Г. Ф., Распопов В. М., Аксёнов В. П., Чипинов В. Г. Биохимические и морфофизиологические показатели русского осетра в современных экологических условиях Волго-Каспия // Тепловодная аквакультура и биологическая продуктивность водоемов аридного климата: сб. материалов и докл. Междунар. симп. Астрахань, 2007. С. 484–486.



